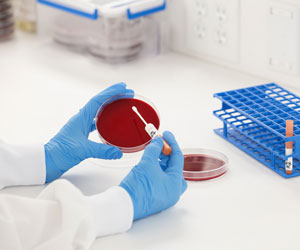

Trusted for over 30 years, KWIK-STIK™ simplifies QC testing with an all-in-one device containing a lyophilized pellet, hydrating fluid, and swab. With 700+ strains available, it supports clinical, food, pharmaceutical, and water testing labs. Save time, reduce contamination risk, and skip the hassle of frozen strains—KWIK-STIK™ delivers reliable, ready-to-use cultures stored at standard refrigeration temps. All with expert technical support at your fingertips.
Key Points:
- Extensive, diverse collection of organisms (700+ strains)
- All-in-one design reduces the risk of contamination
- Stored at standard refrigeration temperatures
- Ready-to-use format saves you time and money
- Online Certificate of Analysis provides detailed strain information
- Traceability to reference cultures ensures authenticity
- Technical Support experts available for guidance